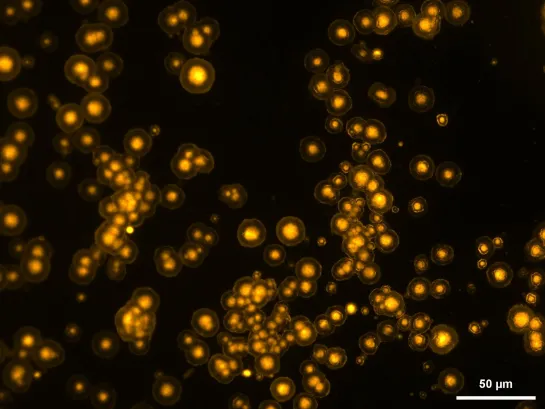

Actualités internationales 4mn
Le bulletin Océan
Les nouvelles de l'Océan - Mai 2025
Tous les mois, plongez dans le Bulletin de l’Océan pour explorer ce qui a fait l'actualité du monde marin.

Au programme
- ONU : moratoire demandé sur l’exploitation des fonds marins
- ADN environnemental : révolution pour observer la vie marine
- Cœlacanthe indonésien observé pour la 1re fois en plongée
- Déchets plastiques en forte baisse sur les plages d’Europe
- Des “super coraux” face au changement climatique
ONU : moratoire demandé sur l’exploitation des fonds marins
Dans un rapport publié en mai 2025, deux expertes de l’ONU appellent à suspendre d’urgence l’exploitation minière des grands fonds marins. Elles mettent en garde contre des dommages potentiels graves et irréversibles pour l’environnement, le climat et les droits humains.
Alors que l’Autorité internationale des fonds marins doit se réunir cet été, l’ONU exhorte les États à se positionner clairement avant toute décision irréversible. Le rapport souligne l’absence de garanties scientifiques et d’une gouvernance solide. Il alerte aussi sur les menaces pour les peuples autochtones, les communautés côtières et les petits États insulaires.

ADN environnemental : révolution pour observer la vie marine
Filtrer de l’eau de mer suffit désormais à révéler la biodiversité qu’elle abrite. Grâce à l’ADN environnemental (ADNe), les scientifiques peuvent identifier poissons, crustacés et micro-organismes sans perturber les écosystèmes.
Déployée sur 45 sites en Méditerranée et à Mayotte par Oceano Scientific et l’entreprise Spygen, cette méthode détecte chaque année des espèces locales et d’autres invasives, comme le crabe bleu.
Associée à l’intelligence artificielle et à des bases de données enrichies depuis 2021, elle permet de cartographier les habitats marins saisonniers et d’identifier des sanctuaires naturels essentiels à la résilience face au réchauffement. Bien que la méthode ne permette pas encore une estimation précise de l’abondance des populations, l’ADNe complète efficacement les observations classiques et éclaire les stratégies de protection marine.
Cœlacanthe indonésien observé pour la 1re fois en plongée
Pour la première fois, un cœlacanthe indonésien (Latimeria menadoensis) a été filmé par des plongeurs à 145 m de profondeur, dans les îles Moluques. Jusqu’alors, l’observation des cœlacanthes indonésiens n’avait été possible que grâce à des robots sous-marins.
L’expédition, dirigée par Alexis Chappuis et menée par l'association UNSEEN en collaboration avec le Muséum national d’Histoire naturelle, l’Université Pattimura d'Ambon et Blancpain Ocean Commitment, visait à mieux comprendre les écosystèmes mésophotiques (30–150 m), zones encore peu explorées où ces poissons sont des indicateurs de la santé des récifs profonds. Cette observation inédite confirme que la plongée humaine, appuyée par des technologies de pointe, reste une voie essentielle pour documenter la biodiversité cachée et orienter sa préservation.

Déchets plastiques en forte baisse sur les plages d’Europe
Une étude du Centre commun de recherche de la Commission européenne, publiée en février 2025, révèle une avancée encourageante : les déchets plastiques ont nettement diminué sur les plages européennes entre 2015 et 2021. Grâce aux efforts conjoints des citoyens, des gouvernements et de l’Union européenne, la quantité totale de macro-déchets a chuté de 29 %, avec une baisse spectaculaire de 40 % pour les plastiques à usage unique.
Les déchets provenant de la pêche ainsi que les sacs plastiques ont eux aussi diminué de 20 %. Ces résultats montrent que les politiques européennes, comme l’interdiction des plastiques jetables et les campagnes de sensibilisation, portent leurs fruits.
Mais le combat continue : pour atteindre les objectifs de pollution zéro, les experts appellent à maintenir le cap et à renforcer les efforts. En attendant, cette tendance à la baisse est une victoire pour l’environnement… et pour toutes celles et ceux qui aiment profiter de plages plus propres.

Des “super coraux” face au changement climatique
En Polynésie française, une équipe menée par la biologiste marine Laetitia Hédouin a découvert des coraux capables de survivre à des températures allant jusqu’à 35 °C, dans le lagon chaud de l’atoll de Tatakoto. Soutenue par l’UNESCO et documentée par le photographe Alexis Rosenfeld, cette mission révèle l’existence de coraux “thermorésistants” qui pourraient jouer un rôle crucial dans la restauration des récifs menacés par le réchauffement climatique. Les scientifiques étudient si cette résistance est durable et transposable ailleurs. Ces “super coraux” représentent un véritable espoir pour préserver la biodiversité marine et renforcer la résilience des océans face aux bouleversements à venir.
